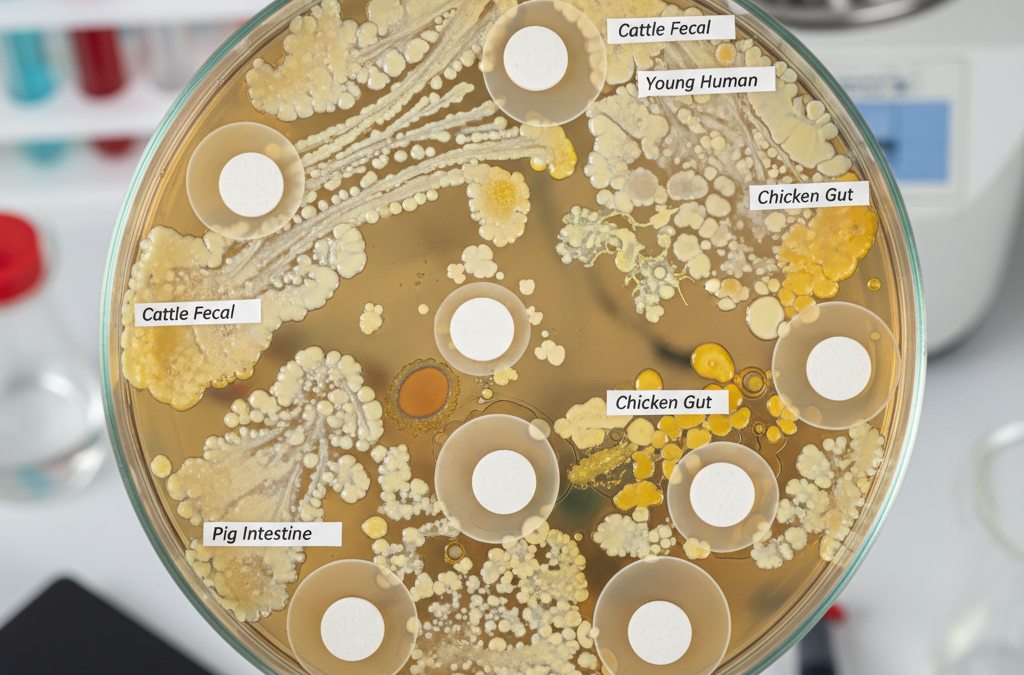

- Odporność na antybiotyki w mikrobiocie jelitowej jest wysoka zaraz po urodzeniu, ale stopniowo spada z wiekiem u ludzi i zwierząt gospodarskich.
- Karmienie mieszanką i diety wysokotłuszczowe lub wysokobiałkowe zwiększają obciążenie genami oporności na antybiotyki (ARG).
- Karmienie piersią oraz diety bogate w błonnik i różnorodne zmniejszają występowanie ARG w jelitach.
- Probiotyki i prebiotyki mogą pomóc w walce z opornością, ale wymagają oceny ryzyka transferu genów oporności.
Co to jest jelitowy resistom i dlaczego jest ważny?
Jelitowy resistom to zbiór genów oporności na antybiotyki (ARG) obecnych w mikrobiocie jelitowej. Odporność na antybiotyki (AMR) stanowi rosnące zagrożenie dla zdrowia globalnego, a badania wskazują na znaczne podobieństwa w genach oporności między jelitami ludzi a zwierząt hodowlanych. To sugeruje możliwość przenoszenia oporności między gatunkami, co podkreśla potrzebę zrozumienia jej rozwoju już we wczesnym okresie życia.
Jak wiek wpływa na rozwój resistomu jelitowego?
U ludzi i zwierząt gospodarskich obserwuje się stały wzorzec: wysoki poziom genów ARG zaraz po urodzeniu, po którym następuje stopniowy spadek z wiekiem. Ten proces jest kluczowy dla projektowania strategii zapobiegania AMR. Zrozumienie tych zmian pozwala na wczesne interwencje chroniące zdrowie publiczne.
Rola diety w modulacji oporności na antybiotyki
Dieta odgrywa decydującą rolę w dynamice resistomu jelitowego. Karmienie mieszanką oraz diety wysokotłuszczowe i wysokobiałkowe wiążą się ze zwiększonym obciążeniem ARG. Z kolei karmienie piersią i zróżnicowane diety bogate w błonnik zmniejszają ich obecność.
Karmienie piersią kontra mieszanka
Karmienie piersią wzbogaca korzystne bakterie, takie jak Bifidobacterium i Lactobacillus, stabilizując ekosystem jelitowy i obniżając poziom ARG. Natomiast karmienie mieszanką sprzyja patogenom oportunistycznym, jak S. epidermidis, K. pneumoniae czy C. difficile, co prowadzi do wyższego poziomu ARG i ruchomych elementów genetycznych (MGE), ułatwiających ich rozprzestrzenianie.
Diety wysokoprzetworzone u zwierząt
Monotonna dieta wysokokoncentratowa, bogata w tłuszcze, białka i cukry, nasila gromadzenie ARG w jelitach zwierząt gospodarskich. To zjawisko zwiększa ryzyko przenoszenia oporności przez łańcuch pokarmowy. Różnorodne diety z błonnikiem mogą temu przeciwdziałać.
Potencjał probiotyków i prebiotyków w walce z AMR
Probiotyki i prebiotyki wykazują obiecujące działanie w zmniejszaniu AMR w jelitach. Jednak przy ich stosowaniu w żywności funkcjonalnej konieczne jest ocenienie ryzyka transferu genów oporności. Podejście to wpisuje się w ramy „One Health”, łączące zdrowie ludzi, zwierząt i środowiska.
Luki w wiedzy i kierunki badań
Przegląd wskazuje na potrzebę dalszych badań nad wczesnym rozwojem resistomu i wpływem interwencji dietetycznych. Kluczowe jest wypełnienie tych luk, by opracować skuteczne polityki i strategie kontroli AMR pochodzącego z jelit. To zapewni ochronę zdrowia publicznego przed narastającą opornością na antybiotyki.
Źródło: Oryginalny artykuł

Komentarze czytelników 3
Temat jest mi niestety bardzo bliski. Po długiej kuracji antybiotykowej, którą musiałam przejść w zeszłym roku przez przewlekłe zapalenie zatok, moje trawienie legło w gruzach. Lekarz niewiele mi podpowiedział poza wykupieniem droższych leków osłonowych, które niewiele dały. Dopiero drastyczna zmiana diety na mniej przetworzoną, odstawienie cukru i ograniczenie mięsa z supermarketów zaczęło przynosić efekty. Czytając takie teksty, utwierdzam się w przekonaniu, że nasza dieta to podstawa. Niestety, w dzisiejszych czasach trudno jest uniknąć antybiotyków w pożywieniu, jeśli nie ma się dostępu do sprawdzonych źródeł mięsa czy nabiału.
To bardzo ciekawy artykuł, szczególnie w kontekście tego, jak współczesne rolnictwo wpływa na nasze zdrowie. Zastanawiam się jednak, czy badania uwzględniły też wpływ suplementacji probiotykami w codziennej diecie? Czy regularne spożywanie kiszonek lub jogurtów naturalnych może realnie osłabić tę oporność u osób starszych, czy to raczej tylko pobożne życzenie? Chciałbym wiedzieć, czy nauka sugeruje jakieś konkretne produkty, które mogłyby pomóc w odbudowie mikrobiomu, bo coraz częściej słyszy się o tym, że jelita to nasz drugi mózg, a antybiotyki niszczą wszystko po drodze.
Warto też dodać, że problem oporności bakterii nie dotyczy tylko jelit, ale również gleby, na którą trafiają odchody zwierząt hodowlanych nawożonych obornikiem. Jeśli w paszach stosuje się antybiotyki, te związki wraz z bakteriami opornymi przenikają do środowiska, a potem wracają do nas wraz z warzywami uprawianymi na takich polach. To zamknięte koło, o którym rzadko mówi się w mainstreamowych mediach. Naukowcy biją na alarm od lat, ale skala problemu w skali globalnej jest ogromna i trudno będzie to zatrzymać bez zaostrzenia przepisów dotyczących stosowania antybiotyków w hodowli przemysłowej.
💬 Co sądzisz? Podziel się swoją opinią
Twój komentarz zostanie opublikowany po moderacji. Adres email nie będzie widoczny.